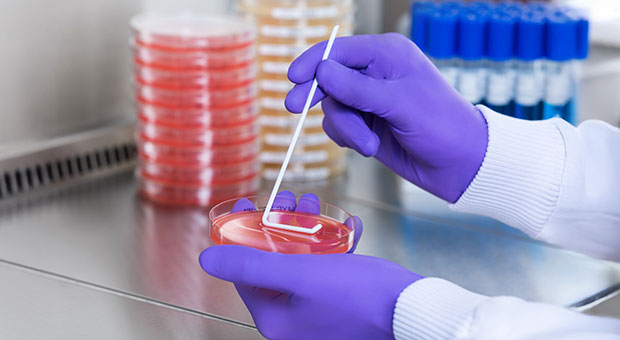
A laboratory technician wearing gloves is using a sterile swab to inoculate a red agar Petri dish

Microbiology: Media Preparation
What is Culture Media?
Microorganisms need nutrients, a source of energy, and certain environmental conditions in order to grow and reproduce. In the natural environment, microbes have adapted to the habitats most suitable for their needs. In the laboratory, however, these requirements must be met by culture media. A culture medium is an aqueous solution to which all the necessary nutrients have been added. Depending on the type and combination of nutrients, different categories of media can be made.

MicrObiological culture media: DIFFERENTIAL, SELECTIVE MEDIA, COMPLEX AND DEFINED MEDIA
Selective and differential media are media based on either complex or defined media supplemented with growth-promoting or growth-inhibiting additives. The additives may be species- or organism-selective. e.g., a specific substrate, or an inhibitor such as cyclohexamide (artidione), which inhibits all eukaryotic growth and is typically used to prevent fungal growth in mixed cultures.
Complex media are rich in nutrients that contain water-soluble extracts of plant or animal tissue (e.g., enzymatically digested animal proteins such as peptone and tryptone). Usually, some sugar, often glucose, is added to serve as the main carbon and energy source. The combination of extracts and sugar creates a medium that is rich in minerals and organic nutrients, but since the exact composition is unknown, the medium is called complex.
Defined media are media composed of pure ingredients in carefully measured concentrations and dissolved in double distilled water (i.e., the exact chemical composition of the medium is known). Typically, they contain a simple sugar as the source of carbon and energy, a source of inorganic nitrogen, various mineral salts, and, if necessary, growth factors (purified amino acids, vitamins, purines, and pyrimidines).
Types of culture media and their importance
The mixture of necessary nutrients can be used as a liquid medium, or a solidifying agent can be added. "Agar agar" is a natural polysaccharide produced by marine algae and is the most commonly used solidifying agent added to media (end concentration usually 1.5 % w/v). If hydrolysis of the agar is suspected, a silica gel is used as a replacement solidifying agent.
Explore our high-quality microbial culture media that can enhance reproducibility and reliability in microbiological testing in your laboratory. Visit Microbial Culture Media webpage.
Protein Hydrolysates
Complex media contain often protein hydrolysate which are are excellent natural sources of amino acids, peptides and proteins in growth media. It is the most important source for nitrogenous nutrients. They are most often obtained by enzymatic digestion or acid hydrolysis of natural products, such as animal tissues, milk, plants or microbial cultures. The number of available protein hydrolsate, also called peptones, is enormous and can promote and sustain the growth of most common organisms. For the enzymatic digestion often papain, pepsin, trypsin or a mixture of enzymes of the pancreatic juice are taken. Below is a list of often used expressions and the definitions.
ASEPTIC TECHNIQUES USED in MICROBIOLOGICAL labs
Before inoculation, it is important to maintain the sterile condition of the microbiological media and all materials it encounters. During any subsequent handling of the bacterial cultures, unwanted or contaminant organisms must be excluded by employing aseptic techniques.
Sterilization implies the destruction of all microorganisms including spores, this is accomplished using heat, chemicals, radiation, and filtration.
Heat Sterilization
Heat sterilization causes denatures and coagulates vital proteins. It is simple to use, effective, easy to control, and cost-effective. There are various forms of heat sterilization.
- Red Heat: Inoculating wires or loops are sterilized by holding them in a Bunsen flame until they are red hot.
- Moist Heat: Bacteria are more readily destroyed by moist heat (steam) than dry heat. Usually used for the sterilization of culture media, aqueous solutions, and the destruction of discarded cultures. Air must first be removed in order to achieve the 121 °C necessary for successful sterilization. This is accomplished by the use of an autoclave (the technical version of a pressure cooker), which follows automatic cycles of heating under pressure for the required time.
- Dry Heat: Usually employed for materials that could either be corroded by steam or must remain dry before use. These include metal instruments, glass Petri dishes, flasks and pipettes, and cotton wool. In practice, dry heat sterilization requires longer time intervals and higher temperatures than steam sterilization (e.g., steam sterilization 121 °C for 15 minutes or dry heat sterilization 160 °C for 120 minutes).
Chemical Sterilization
Chemical sterilization is usually employed for delicate equipment such as optical instruments and electrical devices, which would otherwise be damaged by heat. Due to the toxicity of the chemicals used, this is not the most popular form of sterilization. Chemicals employed include gaseous ethylene oxide, which alkylates amino, sulfhydryl, carboxyl, and hydroxyl groups of microbial cell compounds; formaldehyde, used as a fumigant; and hydrogen peroxide vapor used in aseptic packaging.
Sterilization by Radiation
Radiation is applied for heat-sensitive materials and for environmental samples such as soil and sediment where structural changes caused by heat need to be avoided. Two forms of radiation are used:
- UV Sterilization initiates the excitation of atoms, which in nucleic acids leads to fatal mutations. UV light cannot penetrate materials so is used mainly for surface treatments (e.g., Laminar flow benches, and air and water).
- Ionizing Radiation can penetrate samples, causing ionization within cells. Gamma radiation generated through a 60Co is used to sterilize complex matrices such as soil and foodstuff. Microorganisms show increased resistance to radiation under anoxic conditions (2-5x) and in frozen samples.
Sterilization by Filtration
Filtration sterilization operates through the exclusion rather than the destruction of microorganisms. It is safe for the user and is employed for sensitive liquids and gases. Three types of filters are currently in use:
- Depth Filters are made of columns packed with fibrous materials such as glass wool or cotton wool. The twisting and turning fibers entrap particles and act as filters; they show little resistance to flow and are used mainly for gases or as pre-filters for membrane filters which are easily clogged.
- Membrane Filters act by screening out particles. Their effectiveness depends on the size of the membrane pores and the electrostatic attractions present. The most commonly used filters in microbiology are usually made of cellulose acetate or cellulose nitrate. Membrane filtration is usually employed for heat-sensitive substances, e.g., vitamin solutions; the filters are heat-sterilized before use.
Pore size of membrane filter for screening
- Nucleation Track (Nuclepore) Filters consist of very thin polycarbonate films that have been treated with nuclear radiation and then etched with a chemical to create very uniform vertical holes. They are applied for the same material as membrane filters but are more easily clogged.
Media Supplements
Table of the most commonly used media supplements, methods of sterilization, and solubility.
Media supplements, methods of sterilization, and solubility
All stock solutions of amino acids can be autoclaved at 120 °C for 20 mins.
Interaction of Media Components
When undertaking research where medium composition plays an important role, (e.g. toxicity studies), care must be taken to observe the various interactions which can take place between media components.
* Can be avoided by addition of a HEPES buffer to reduce phosphate.
Optimize Microbial Growth with Our Culture Media Solutions
We provide a diverse selection of high-quality products tailored to meet your microbiological testing needs. Our offerings include both dehydrated and ready-to-use culture media, which are formulated with essential nutrients, energy sources, and growth-promoting factors crucial for cultivating microorganisms. These formulations are carefully designed to ensure precise, reproducible, and consistent test results, in compliance with industry standards and regulatory guidelines. Furthermore, our portfolio features specialized media that can be enhanced with neutralizers, allowing for the growth of organisms even in the presence of antimicrobial agents. This versatility makes our products ideal for a wide range of applications in research and quality control. For more information, please visit our Microbial Culture Media page.

To continue reading please sign in or create an account.
Don't Have An Account?